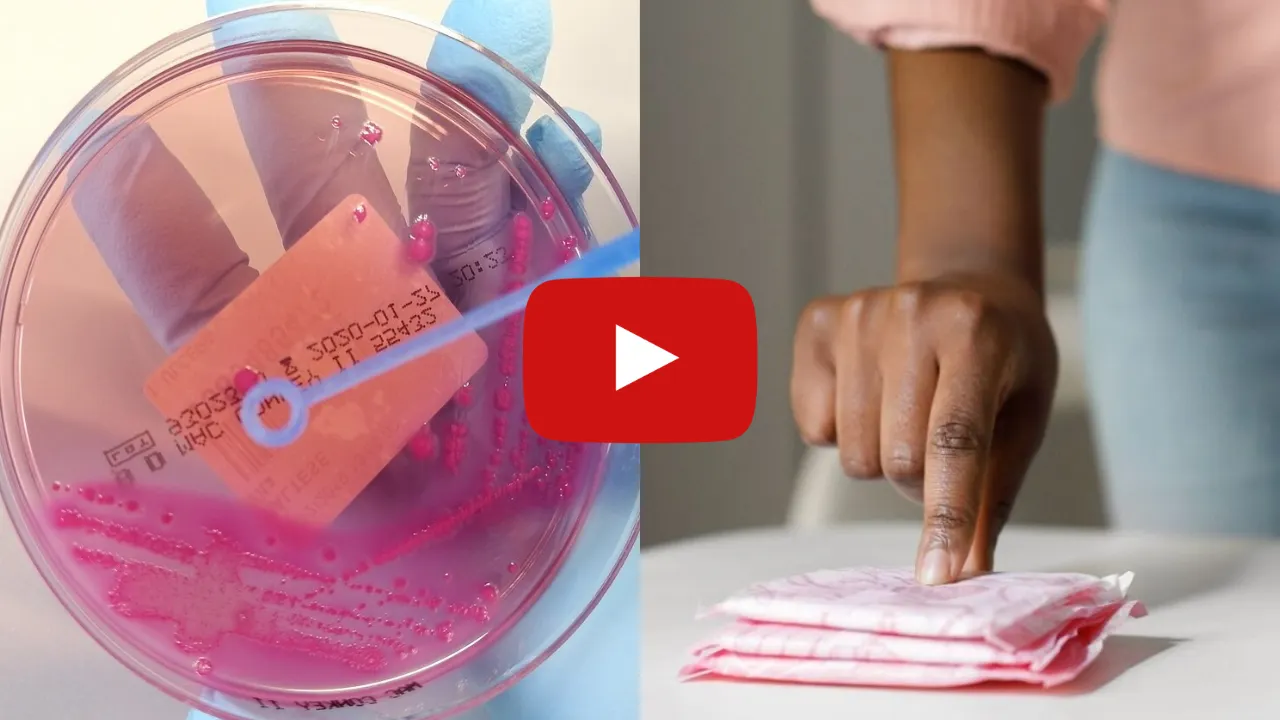

Daily Research
Post: 9 hours ago | Plays: 34,113
Scientists Warn of Hidden Chemicals in Women’s Hygiene Products
For years, most women have trusted the same name-brand pads and tampons — never suspecting they could be part of the problem.
Now, research from top universities is revealing that a common chemical found in many feminine products may quietly disrupt the bladder’s natural balance.
When that balance is disturbed, irritation and discomfort can follow — leaving many feeling frustrated and confused about why nothing seems to help.
The good news is, scientists have identified a simple, 7-second method to help your body reset that balance safely — without pills, surgery, or complicated routines.
Thousands are already finding relief and confidence again using this gentle approach.
If you’ve want to try for yourself, tap the button below to see this special video guide that shows you the exact technique that you can do at home tonight.